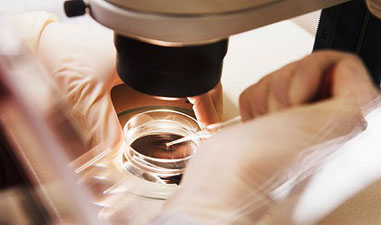

最近,‘美国动物保护协会’公共卫生和动物农业部主任迈克尔·格雷格,写了一篇关于从动物传布的传染病惊人地上升的特别CNN报道。格雷格说:“在一个屋顶下,几万到几十万头动物被关在笼子里,这为人畜共患疾病的出现、扩大和传播创造了条件”。根据‘国际牲畜研究所’的报告,人畜共患传染病造成全球每年大约25亿人患病, 270万人死亡。格雷格主任强调随着肉类消费的增加,患传染性疾病的人数也在上升。此外,格雷格指出,在美国减少传染病发病率最有效的方式来是关怀在农场中动物的动物福利和将牲畜从它们的围笼中释放出来。
翻译:合川
原文:Report: New research shows that roughly 75 percent of infectious diseases originate from animals